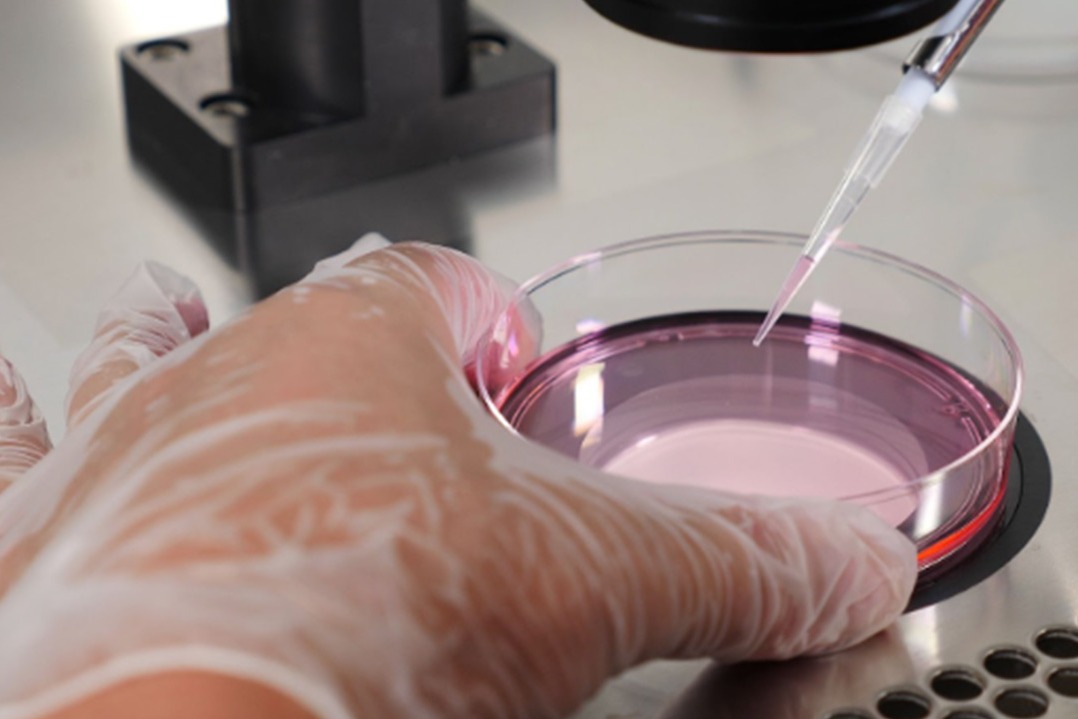

+918462932502

This is your website preview.
Currently it only shows your basic business info. Start adding relevant business details such as description, images and products or services to gain your customers attention by using Boost 360 android app / iOS App / web portal.
Looking for trusted and advanced fertility care in Indore? 🌸 Dr. Ishita Ganguly, a leading IVF Spe...
Looking for trusted and advanced fertility care in Indore? 🌸 Dr. Ishita Ganguly, a leading IVF Specialist in Vijay Nagar, Indore, is dedicated to helping couples achieve their dream of parenthood with compassion and expertise. As a highly experienced lady doctor and one of the best gynecologists in the region, she provides personalized care tailored to every patient’s unique needs. ✨ Why choose Dr. Ishita Ganguly? ✔ Advanced IVF treatments with high success rates ✔ Comprehensive gynecological care under one roof ✔ Patient-friendly approach with ethical guidance ✔ Modern technology and state-of-the-art facilities ✔ Comfortable and supportive environment for women Whether you’re seeking fertility solutions, expert gynecological advice, or the best IVF centre in Indore, Dr. Ishita Ganguly ensures you receive trusted, result-oriented care every step of the way. 💖 Begin your journey towards parenthood with confidence. 📍 Conveniently located in Vijay Nagar, Indore Book your consultation today and take the first step toward a healthier, happier future. क्या आप इंदौर में विश्वसनीय और उन्नत फर्टिलिटी केयर की तलाश में हैं? 🌸 डॉ. इशिता गांगुली, विजय नगर, इंदौर की एक प्रमुख IVF विशेषज्ञ, दंपत्तियों को माता-पिता बनने के सपने को साकार करने में समर्पित हैं। एक अनुभवी लेडी डॉक्टर और क्षेत्र की बेहतरीन स्त्री रोग विशेषज्ञों में से एक होने के नाते, वे हर मरीज को उनकी जरूरत के अनुसार व्यक्तिगत और संवेदनशील देखभाल प्रदान करती हैं। ✨ डॉ. इशिता गांगुली को क्यों चुनें? ✔ उच्च सफलता दर के साथ उन्नत IVF उपचार ✔ एक ही स्थान पर संपूर्ण स्त्री रोग सेवाएं ✔ मरीजों के प्रति संवेदनशील और नैतिक दृष्टिकोण ✔ आधुनिक तकनीक और अत्याधुनिक सुविधाएं ✔ महिलाओं के लिए सुरक्षित और आरामदायक वातावरण चाहे आपको फर्टिलिटी उपचार की आवश्यकता हो, विशेषज्ञ स्त्री रोग सलाह चाहिए या इंदौर के बेहतरीन IVF सेंटर की तलाश हो—डॉ. इशिता गांगुली हर कदम पर भरोसेमंद और परिणाम-आधारित देखभाल सुनिश्चित करती हैं। 💖 आत्मविश्वास के साथ अपनी पैरेंटहुड यात्रा की शुरुआत करें। 📍 सुविधाजनक स्थान: विजय नगर, इंदौर आज ही अपनी अपॉइंटमेंट बुक करें और एक स्वस्थ व खुशहाल भविष्य की ओर पहला कदम बढ़ाएं।

